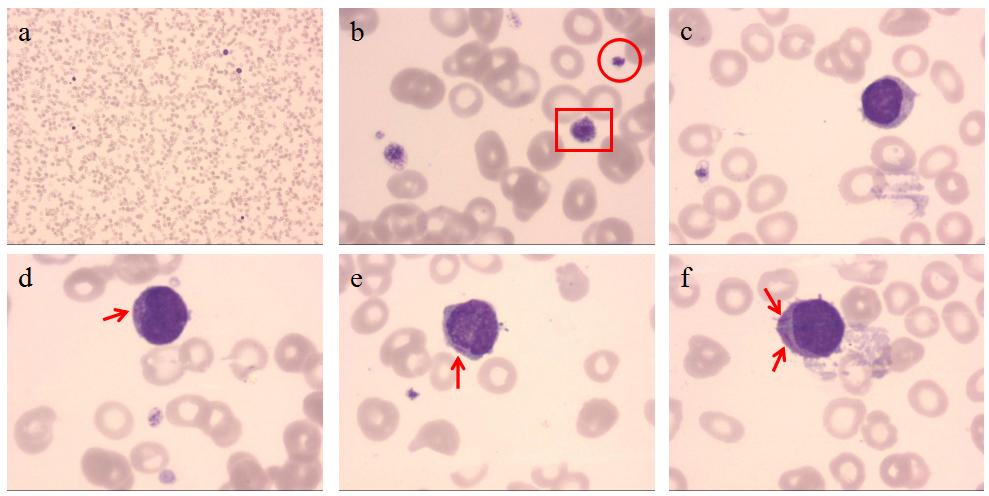

科技改变生活 · 科技引领未来
cription-url="http://mmbiz.qpic.cn/mmbiz_jpg/oibBq71TGAe5nBiaiay8cBdJLIuJjOEpJNJkSRtnOudkLJrvknnDRpswU1hcZU7lKicXoQBcCnUaKR5CgeGv7vtTzQ/0?wx_fmt=jpeg" data-type="jpeg" data-before-oversubscription-url="http://mmbiz.qpic.cn/mmbiz_png/oibBq71TGAe7ibNI5DyTyibMNm3uvJ1tiaRyBK4ibW9scS9YbY3wW4hY18IevSjQic1yVDJOLnb8EngSLgxtZaLG6NEg/640?wx_fmt=png" data-w="678" style="max-inline-size: 100%;z-index: -1;cursor: pointer;color: rgb(0, 0, 0);text-align: center;caret-color: rgb(255, 0, 0);background-color: rgb(255, 255, 255);width: 100%;font-family: 微软雅黑, Arial, sans-serif;box-sizing: border-box !important;outline: none 0px !important;height: auto;" data-backh="86" data-backw="574">作者:潘平
单位:杭州市妇产科医院检验科

妇产科医院的常规血液检验中,最常见的异常结果基本是妊娠期生理性贫血引起的红细胞和血红蛋白降低、分娩前后出现的白细胞及血红蛋白的节律性变化、肿瘤术后放化疗过程中白细胞降低、新生儿外周血涂片中出现一过性的生理性有核红细胞等。虽然日常标本以正常结果为主,但对异常结果的把关与特殊细胞的鉴别我们时刻没有松懈。今天就请大家一起来看一下,我们是如何从这些常规的血液检验数据中凭着练就的火眼金睛,发现一位更年期门诊女性的极早期M3型白血病。
案例经过
患者,52岁,女性,因月经不规则等就诊于我院更年期门诊。血液常规检验结果:白细胞1.54×109/L「正常女性参考区间(3.5~9.5)×109/L」,且以中性粒细胞绝对值降低为主。同时伴有红细胞减少(2.67×1012/L)、血小板下降(78×109/L)(图1)。

图1
仪器显示散点图和直方图提示异常,报警信息提示“异常淋巴细胞/原始细胞”(图1)。
考虑该患者已有52岁,尽管病史中未提到有发热等特殊症状,但还是引起了足够的重视。按实验室的复检规则,对该患者的标本进行血涂片染色镜检,借助显微镜的力量来查看一下真实的情况。同时,对血小板进行光学法和手工显微镜计数复核。
涂片镜检显示,该患者显微镜下白细胞数量明显减少,且可以看到极少量的疑似幼稚粒细胞(图2a);此外,相比正常的红细胞,该患者红细胞中心淡染区扩大明显,说明确实有贫血存在;与此同时,显微镜下患者的血小板体积大小不一(图2b)。
血涂片复核显示,尽管由于患者白细胞总数下降,在显微镜下能计数到的细胞数很少,但最终通过仔细扫描全片,还是在显微镜下找到了典型的幼稚细胞,并隐约能看到胞质中含有Auer小体(Auer小体常出现在急性粒细胞性白血病中,可作为白血病的鉴别特征)(图2d-2f)。
图2
注:图2a白细胞数量减少;图2b大小不一的血小板,方框处为大血小板,圆圈处为正常大小的血小板;图2c-2f早幼粒细胞,箭头所指处为Auer小体(图2a:×100;图2b-2f:×1000)。
案例分析
综合以上结果,基本确定该患者的血液常规结果要考虑白血病的可能。随后第一时间电话联系首诊医生,告知患者的血常规结果异常情况,并请医生建议患者尽快去综合性医院血液科就诊。门诊医生两天后电话告知该患者至外院检查后确诊为极早期的M3。由于发现得早,给患者争取到了早诊断和早治疗的宝贵时间。
总结
M3型白血病(急性早幼粒细胞白血病,APL)是以异常早幼粒细胞增生为主的急性白血病(AML)。APL易见于中青年人,平均发病年龄为44岁,除白血病常见的特征外,M3以其严重的并发症而使其异于常规白血病的治疗。
M3极易导致DIC,出血以皮肤、粘膜为主,若未及时进行白血病类型的甄别,及早获得准确的治疗方案,死亡率极高。
目前,治疗M3以全反式维甲酸(ATRA)及砷剂的规范化临床应用为主要手段,也正因为该方案的实施,APL已成为基本不用进行造血干细胞移植即可治愈的白血病,是目前医学上认为治疗效果最好的白血病类型,治愈率常常高达90%。
谈到白血病,大家都是避之不及,其实部分白血病若能早期发现,早期精准治疗,可大大提高治愈率。提醒大家不要对常规检查掉以轻心,需重视每一次的检查结果。
参考文献:
1. 中国急性早幼粒细胞白血病诊疗指南(2018年版)
